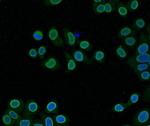
Lamin B2 Antibody in Immunocytochemistry (ICC/IF)

Search
Invitrogen
Lamin B2 Polyclonal Antibody
{{$productOrderCtrl.translations['antibody.pdp.commerceCard.promotion.promotions']}}
{{$productOrderCtrl.translations['antibody.pdp.commerceCard.promotion.viewpromo']}}
{{$productOrderCtrl.translations['antibody.pdp.commerceCard.promotion.promocode']}}: {{promo.promoCode}} {{promo.promoTitle}} {{promo.promoDescription}}. {{$productOrderCtrl.translations['antibody.pdp.commerceCard.promotion.learnmore']}}
图: 1 / 5
Lamin B2 Antibody (PA5-85915) in ICC/IF

Please note: We are reviewing Western blot images included in the antibody testing data in our catalog, including those provided by third parties. Unless expressly labeled or annotated as “raw-unedited”, Western blot images included in the antibody testing data in our catalog may have been edited, optimized or otherwise adjusted for presentation.
产品信息
PA5-85915
种属反应
已发表种属
宿主/亚型
分类
类型
抗原
偶联物
形式
浓度
规格
纯化类型
保存液
内含物
保存条件
运输条件
RRID
靶标信息
Nuclear lamins form a network of intermediate-type filaments at the nucleoplasmic site of the nuclear membrane. Two main subtypes of nuclear lamins can be distinguished, i.e. A-type lamins and B-type lamins. The A-type lamins comprise a set of three proteins arising from the same gene by alternative splicing, i.e. lamin A, lamin C and lamin Adel 10, while the B-type lamins include two proteins arising from two distinct genes, i.e. lamin B1 and lamin B2. Recent evidence has revealed that mutations in A-type lamins give rise to a range of rare but dominant genetic disorders, including Emery-Dreifuss muscular dystrophy, dilated cardiomyopathy with conduction-system disease and Dunnigan-type familial partial lipodystrophy. In addition, the expression of A-type lamins coincides with cell differentiation and as A-type lamins specifically interact with chromatin, a role in the regulation of differential gene expression has been suggested for A-type lamins.
仅用于科研。不用于诊断过程。未经明确授权不得转售。
生物信息学
蛋白别名: lamin B2; lamin B3; Lamin-B2; MGC2721
基因别名: LMN2; LMNB2; RGD1563803
UniProt ID: (Mouse) P21619
Entrez Gene ID: (Mouse) 16907, (Rat) 299625




